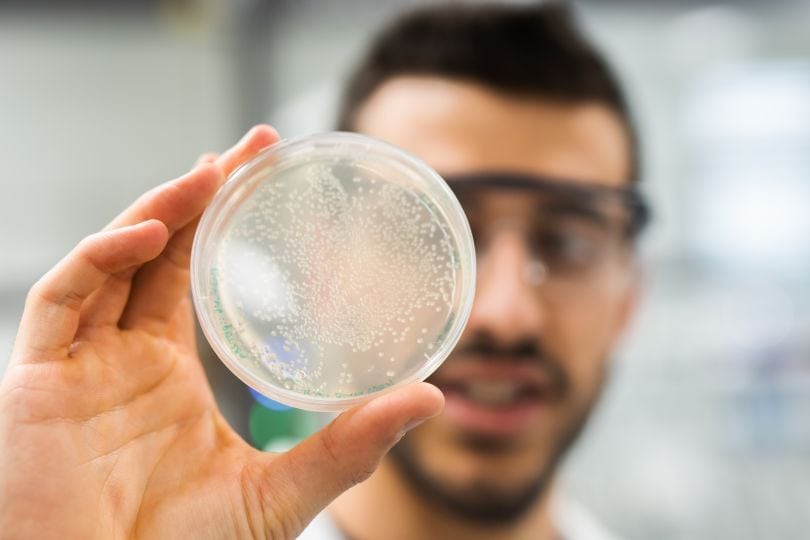

Das war das Jahr 2023
Das Jahr 2023 – Rekord-Investments und fast 280 Millionen Euro Projektvolumen gehebelt
- Insgesamt haben wir 1.479 Projekte steirischer Unternehmen mit rund 53,3 Millionen Euro (gespeist aus Landes- und EU-Mitteln) unterstützt.
- Davon entfielen 49.504.582 Euro auf Förderungen (von Cluster- und COMET-Förderungen über Investitions- und Innovationsprogramme für KMU bis hin zur Gründungsförderung für Selbstständige).
- Die Summe unserer Investments in den Aufbau junger Unternehmen hat sich im Vergleich zum Vorjahr mehr als verdreifacht: Sie stieg von rund 1 auf knapp 3,8 Millionen Euro.
- Mit 14 Beteiligungen beschlossen wir so viele Finanzierungen wie noch nie in der Unternehmensgeschichte der SFG.
- Insgesamt hebelten die Maßnahmen ein Investitionsvolumen von knapp 280 Millionen Euro (anrechenbare) Projektkosten.
- Fast ein Viertel der Unterstützungen kamen Startups in der Gründungs- bzw. Wachstumsphase zugute. Mehr als jede zweite Förderung betraf den Bereich Qualifizierung und Humanpotenzial.
- Das Ranking der aktivsten Bezirke: Graz, Graz-Umgebung, Weiz, Hartberg-Fürstenfeld sowie Südoststeiermark. Danach folgen Leibnitz, Deutschlandsberg und Bruck-Mürzzuschlag.
Unternehmens-Support und Highlights im Oktober/November/Dezember 2023
Das waren unsere "Unternehmen des Monats"
Die Top 3 der beschlossenen Förderungen im Jahr 2023
Best of Juli/August/September 2023
Im Sommer und Frühherbst haben wir durchgeatmet und neue Kraft geschöpft – sind dabei aber nicht untätig gewesen! So starteten wir die 3. Auflage des begehrten Innovationspreis Steiermark, investierten in Spielfreude und Teamgeist am Arbeitsplatz, legten 3 temporäre EFRE-Förderungsmaßnahmen auf, stärkten regionale Lebensmittelmarken und freuten uns über 1 Million Euro EU-Direktförderung für KMU im Bereich Digital Health.
Zieleinläufe, Stories & Projekte
Das waren unsere "Unternehmen des Monats"
Die Top 3 der beschlossenen Förderungen in Q3/2023
Best of April/Mai/Juni 2023
In den zweiten drei Monaten des Jahres reisten wir vorwärts in die Zukunft, investierten in die europäische Antwort auf ChatGPT, sind geradelt und geschwommen, brachten eine neue Förderung für IT-Sicherheit auf den Markt, konzipierten niederschwellige Online-Pitchings für Startups, gaben Spitzenforschung mehr Raum und knüpften Gründernetzwerke nach Slowenien.
Zieleinläufe, Stories & Projekte
Das waren unsere "Unternehmen des Monats"
Die Top 3 der beschlossenen Förderungen in Q2/2023
Best of Jänner/Februar/März 2023
Die ersten drei Monate des Jahres brachten Dynamik! Mehr Geld für Investments, mehr Bewegung im Smart Business Center, sechsmal Siegesfreude beim Innovationspreis Steiermark, mehr Schub für Life-Science-Startups im neuen ZWT-Accelerator sowie mehr Wissen für unsere Kundinnen und Kunden (122 Förderungsbeschlüsse in Weiter!Bilden). Machen Sie sich ein Bild!
Zieleinläufe, Stories & Projekte
Das waren unsere "Unternehmen des Monats"
Die Top 3 der beschlossenen Förderungen in Q1/2023

Stv. Verantwortliche Kommunikation
+43 316 7093 200, +43 664 80793 200